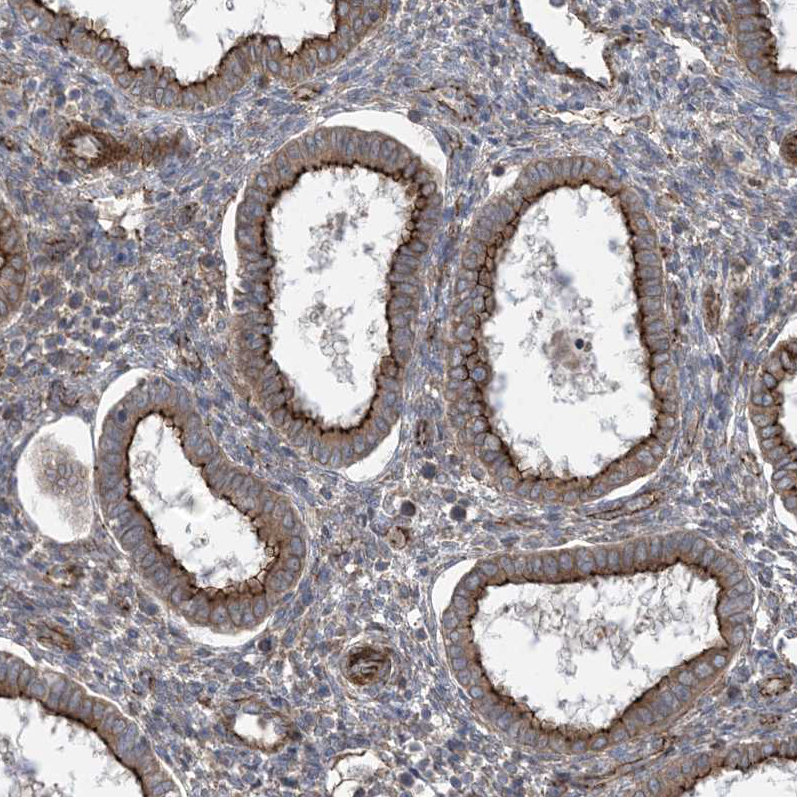
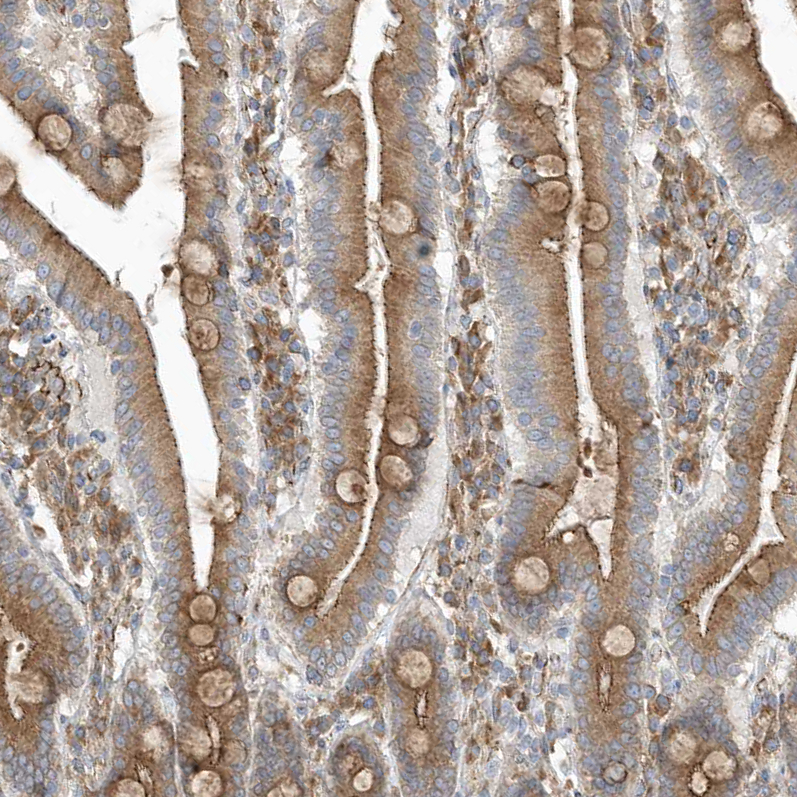
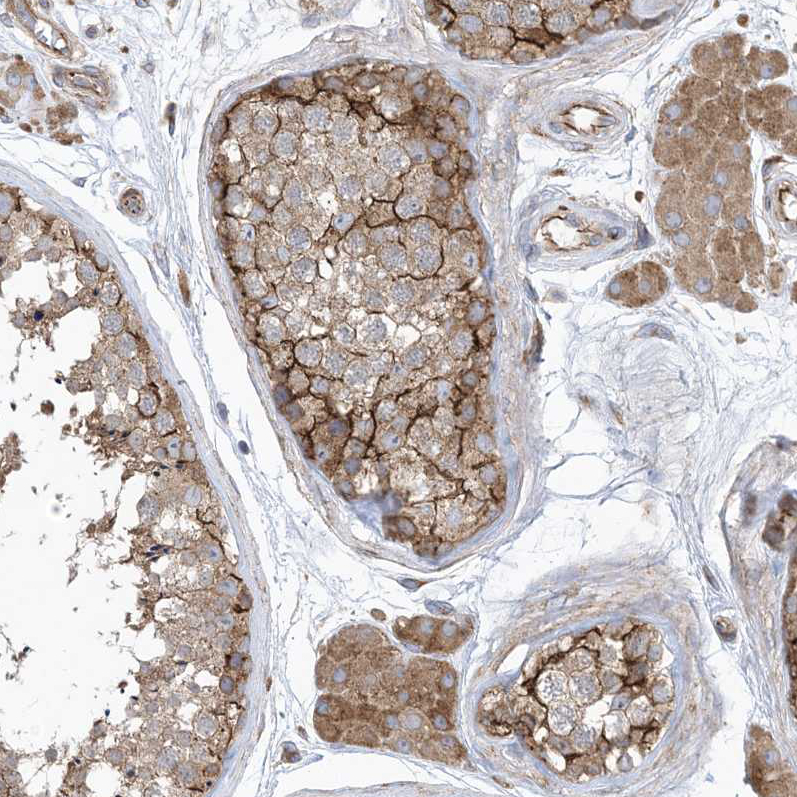

All products are designed for the highest possible performance and are manufactured using a standardized process to ensure the most rigorous levels of quality.
The Anti‑OTOP1 antibody (HPA035599) is a highly specific, affinity‑purified polyclonal antibody developed in rabbit and designed to target OTOP1, a proton‑selective ion channel crucial for sensory physiology and cellular pH regulation. Validated primarily for immunohistochemistry (IHC), this antibody demonstrates strong membranous positivity in human tissues such as kidney glomeruli, endometrium, duodenum, and testis, making it a powerful tool for researchers studying epithelial ion transport and vestibular biology.
Significance in Research: OTOP1 plays a key role in proton transport, contributing to intracellular pH regulation, vestibular function, and sensory perception. It is essential for otoconia formation in the inner ear, influencing balance and spatial orientation, and is implicated in calcium homeostasis through purinergic signaling pathways. Dysregulation of OTOP1 function is associated with impaired vestibular signaling, altered taste perception, and metabolic disturbances.
Corresponding antigens
With Atlas Antibodies you get

From our facilities in Stockholm, Sweden we develop, manufacture and distribute highly advanced reagents to the Life Sciences community worldwide.

Our products are available to customers worldwide. From most locations, you can order our products from Atlas Antibodies. Please see more information about how to order here.

Learn how we validate our antibodies, how we secure their reproducibility, and why we apply enhanced validation. Our antibodies are validated in IHC, ICC-IF, and WB.